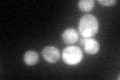
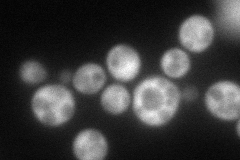
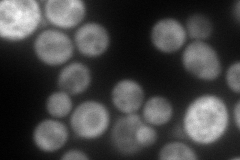
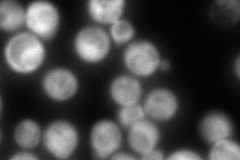
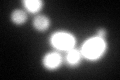
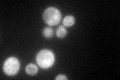

View description
Phosphoribosylaminoimidazole carboxylase, catalyzes a step in the 'de novo' purine nucleotide biosynthetic pathway; red pigment accumulates in mutant cells deprived of adenine
Localization:
Intensity:
Fold change:
Significance:
-
C’ GFP library in SD
cytosol90.34 -
N' NOP1pr-GFP in SD
cytosol105.099 -
N' TEF2pr-mCherry in SD
cytosol182.89 -
N' NATIVEpr-GFP in SD
cytosol215.311 -
N' TEF2pr-VC and Cyto-VN in SD

#N/A0 -
C’ GFP library in SD+DTT
cytosol92.391.02No -
C’ GFP library in SD+H2O2

cytosol111.251.23No -
C’ GFP library in Starvation Media
cytosol143.851.59Yes -
C’ GFP library on the background of Pup2-DaMP

cytosol -
C’ GFP library on the background of CCT mutant

cytosol97.45561.07869No
